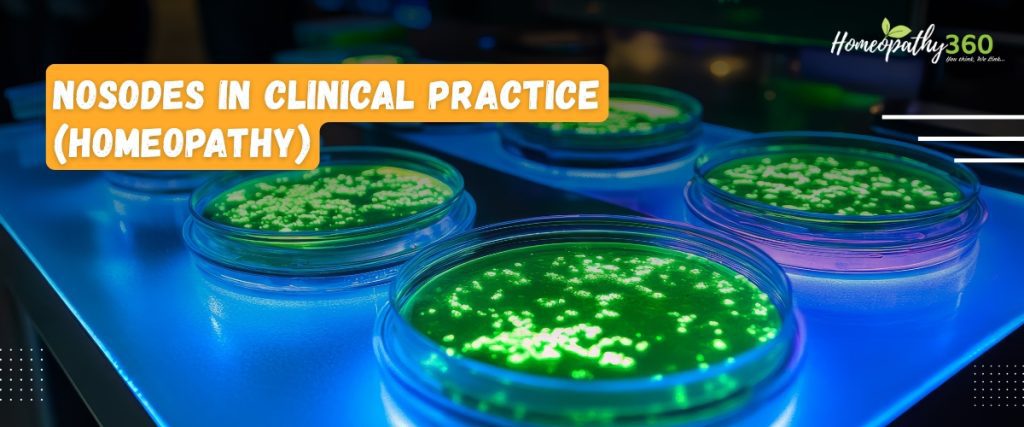

Nosodes in Clinical Practice (Homeopathy)
Abstract:-Nosodes play an important role in the management of chronic diseases by acting on the underlying miasmatic background, thereby improving the patient’s constitutional state and enhancing the action of indicated remedies.
Keyword :- Nosodes , how and when to use.
Introduction
• The word nosode comes from the Greek word “nosos” , which means disease.
• In Homeopathy, nosodes are remedies prepared from pathological substances such as diseased tissues, microbial cultures, or pathological secretions. These substances are processed through serial dilution and potentization according to homeopathic pharmacopeia, making them safe for therapeutic use.
• The concept of nosodes was introduced in the 19th century and further developed by pioneers such as Constantine Hering, James Compton Burnett, and J.H. Allen. Nosodes are mainly used in chronic diseases, miasmatic conditions, and cases where well-selected remedies fail to act.
Definition
A Nosode is a homeopathic preparation derived from:
• Diseased tissue,
• Pathological secretions or excretions
• Microbial cultures (bacteria, viruses)
• Products of disease
• These substances are potentized to eliminate toxicity while retaining therapeutic properties. Classification of Nosodes
Nosodes are generally classified into three groups:
1. Bacterial Nosodes
Prepared from bacteria or bacterial cultures.
Examples::
A) Tuberculinum
–Introduction-Tuberculinum is a nosode prepared from tubercular material (infected lung tissue or sputum containing Mycobacterium tuberculosis). It is widely used in homeopathy for tubercular diathesis and chronic, recurrent conditions.
Keynote Theme
• “Constant change, dissatisfaction, and destruction”
• Desire for change, travel, restlessness
• Easily bored, wants new things frequently
• Deep miasmatic remedy (mainly tubercular miasm)
Constitution (Personality Type)
Mental Symptoms
• Irritable, destructive behavior (children break toys)
• Restless, never satisfied
• Anxiety about health
• Sudden mood changes
• Desire to travel constantly
• Aversion to mental work but active imagination
Emotional Traits
• Feels trapped or restricted
• Impulsive, rebellious nature
• Fear of dogs, animals (in some cases)
Physical Constitution
• Thin, narrow chest, weak build
• Recurrent colds, cough, bronchitis • Tendency to tuberculosis-like symptoms • Enlarged glands
• Sweating (especially at night)
Clinical Indications:-
Respiratory System
• Chronic cough, recurrent bronchitis • Tubercular tendency
• Asthma with restlessness
Skin
• Ringworm, eczema
• Itching better in open air
Nervous System
• Hyperactivity in children
• ADHD-like symptoms
Bones & Joints
• Weakness, pains, early fatigue
Modalities
Better
• Open air
• Closed room
• Motion, travel
Worse
• Rest, confinement
• Dry weather
• Damp, cold weather
Desires & Aversions
Strong desire for: smoked meat, cold milk
Aversion to:
• fatty foods
• Increased appetite but weak digestion
Tuberculinum Child
• Very active, naughty, destructive
• Wants to travel or go outside
• Frequent infections (tonsillitis, colds)
• Thin but eats well
Potency & Dose
• Commonly used in 200C, 1M
• Given in single doses at long intervals
B)Bacillinum
Introduction:-Bacillinum is a nosode prepared from tubercular lung tissue (infected with Tuberculosis bacilli). It is widely used in homeopathy, especially in chronic and recurrent respiratory conditions and tubercular diathesis.
Source & Preparation
• Derived from diseased lung tissue of tuberculosis patients
• Introduced by Dr. James Compton Burnett
• Potentized according to homeopathic pharmacopeia
Miasmatic Background
• Strongly related to Tubercular miasm (combination of psora + sycosis + syphilis) • Indicates deep-seated chronic pathology
Constitution (Personality & Build)
• Lean, narrow-chested individuals
• Poor immunity, frequent infections
Mentally:
• Irritable, restless
• Desire for change, dissatisfaction
• Anxiety about health
Children:
• Delayed growth
• Recurrent colds and cough
Key Indications
1. Respiratory System
• Chronic cough with thick sputum
• Recurrent bronchitis, asthma
• Tubercular tendency
• Enlarged tonsils, adenoids
Note :- Especially useful when symptoms resemble Pulmonary tuberculosis but are not fully developed
2. Skin Disorders
• Ringworm, eczema
• Chronic, non-healing skin eruptions
• Itching worse at night
3. Glands & Lymphatic System
• Enlarged cervical glands
• Scrofulous conditions
4. General Symptoms
• Weakness, easy fatigue
• Sweating, especially at night
• Recurrent fever with chills
Modalities
Aggravation (Worse):
• Cold air
• Damp weather
• Night
Amelioration (Better):
• Warmth
• Open air (sometimes)
• Rest
Clinical Uses
• Chronic recurrent respiratory infections
• Allergic bronchitis
• Asthma with tubercular history
• Adenoids in children
• Chronic eczema
Complementary Remedies:
• Tuberculinum
• Calcarea carbonica
• Phosphorus
• Compare with:
• Psorinum (more filthy, chilly)
• Medorrhinum (sycotic traits)
Dosage & Repetition
• Usually given in high potencies (200C, 1M)
• Single dose followed by observation
• Repetition only after clear indication
C)Staphylococcinum
Introduction
• Staphylococcinum is a homeopathic nosode prepared from toxins or cultures of the bacteria Staphylococcus (especially Staphylococcus aureus).
• It is mainly used in suppurative (pus-forming) conditions and chronic infections.
Source & Preparation
• Derived from cultures of staphylococcal organisms
• Potentized according to homeopathic principles
• Acts deeply on blood, skin, glands, and immune system
Miasmatic Background
• Sycotic miasm (suppuration, overgrowth)
• Mixed miasmatic states in chronic infections
Constitution
• Recurrent infections
• Boils and abscesses
• Weak immunity
• Mental traits:
• Irritable
• Sensitive to pain
• Low vitality
Key Indications
1. Skin & Suppuration
• Recurrent boils, abscesses
• Carbuncles
• Acne with pus formation
• Infected wounds
• Strong indication in Furunculosis
2. Blood & Septic Conditions
• Septicemia tendency
• Post-surgical infections
• Infected ulcers
3. ENT & Glandular Issues
• Tonsillitis with pus
• Sinusitis with thick discharge • Enlarged, suppurating glands
4. Urinary & Genital Infections
• Recurrent urinary infections • Gonorrheal complications
• Suppurative genital infections
Modalities
Aggravation (Worse):
• Cold and damp weather
• Night
• Infection or injury
Amelioration (Better):
• Warmth
• Rest
Clinical Uses
• Boils and abscesses
• Acne vulgaris (pus-filled)
• Recurrent infections
• Post-operative infections
• Chronic suppurative diseases
Relationship with Other Remedies
Complementary Remedies:
• Hepar sulphuris calcareum
• Silicea
• Calcarea sulphurica
Compare with:
• Pyrogenium (septic states with fever)
• Arsenicum album (burning pains, restlessness)
Dosage & Repetition
• Common potencies: 30C, 200C, 1M
• Usually given in single dose or infrequent repetition
2. Viral Nosodes
Prepared from viral material.
Examples:
- Influenzinum
Introduction
• Influenzinum is a homeopathic nosode prepared from influenza virus material. • It is mainly used for prevention and treatment of influenza-like illnesses and recurrent viral infections.
Source & Preparation
• Prepared from influenza virus (commonly seasonal strains) • Potentized according to homeopathic pharmacopeia • Acts on respiratory system, nervous system, and immune system
Miasmatic Background
• Mostly acute miasm
• Sometimes linked with tubercular tendency in recurrent cases
Constitution
Individuals prone to:
• Frequent colds and flu
• Low immunity
• Seasonal infections
Mental state:
• Weakness and dullness
• Irritability during illness
• Mental fatigue
Key Indications
1. Respiratory System
• Sudden onset fever with chills
• Dry or productive cough
• Running nose, sneezing
• Sore throat
2. General Symptoms (Flu-like)
• Body ache, especially back and limbs
• Headache
• Extreme weakness and prostration
• Fever with sweating
3. Nervous System
• Post-influenza weakness
• Neuralgia after viral infection
• Fatigue and slow recovery
4. Recurrent Infections
• Frequent viral attacks
• Helps improve resistance
Modalities
Aggravation (Worse):
• Cold exposure
• Seasonal changes
• Winter
Amelioration (Better):
• Rest
• Warm environment
• Fluids
Clinical Uses
• Acute influenza
• Viral fever
• Preventive during flu outbreaks
• Post-viral fatigue
• Recurrent upper respiratory infections
Prophylactic Use (Important)
• Commonly used as preventive remedy during flu epidemics • Given weekly or monthly in suitable potency (e.g., 30C / 200C)
Relationship with Other Remedies
Complementary Remedies:
• Gelsemium (dullness, weakness)
• Eupatorium perfoliatum (severe body pains)
• Bryonia alba (dryness, thirst)
• Compare with:
• Baptisia tinctoria (toxic, septic state)
• Arsenicum album (restlessness, anxiety)
Dosage & Repetition
• Common potencies: 30C, 200C
• Acute cases: repeated doses
- Morbillinum
Introduction
• Morbillinum is a homeopathic nosode prepared from the virus of measles. • It is used in acute measles cases, complications, and chronic conditions arising after infection.
Source & Preparation
• Prepared from measles virus material
• Potentized as per homeopathic pharmacopeia
Acts mainly on:
• Skin
• Respiratory system
• Nervous system
Miasmatic Background
• Primarily acute miasm
• May show tubercular tendency in chronic after-effects
Constitution
Children or adults with:
• History of measles
• Recurrent respiratory infections
• Weak immunity
Mental state:
• Irritable
• Weak, dull
• Slow recovery after illness
Key Indications
1. Measles (Acute Stage)
• Fever with catarrhal symptoms
• Red rash over body
• Cough and coryza
• Photophobia
2. Respiratory Complications
• Bronchitis after measles
• Persistent cough
• Recurrent colds
3. Skin Disorders
• Suppressed eruptions
• Delayed appearance of rash
• Chronic skin issues after measles
4. Nervous System
• Post-measles weakness
• Neurological complications (rare but important)
Modalities
Aggravation (Worse):
• Cold air
• Suppression of rash
• Night
Amelioration (Better):
• Warmth
• Rest
Clinical Uses
• Measles (early and eruptive stage)
• Complications of measles
• Chronic cough after measles
• Delayed or suppressed eruptions
• Recurrent infections in children
Prophylactic Use
• Sometimes used during measles outbreaks as preventive • Helps reduce severity and complications
Relationship with Other Remedies
Complementary Remedies:
• Pulsatilla
• Belladonna
• Sulphur
• Compare with:
• Aconitum napellus (early fever stage)
• Bryonia alba (dry cough, thirst)
Dosage & Repetition
• Common potencies: 30C, 200C
• Acute cases: repeated doses as required
• Chronic/post-infectious: single dose with observation
- Parotidinum
Introduction
• Parotidinum is a homeopathic nosode prepared from the virus causing mumps. • It is mainly used in mumps and its complications, especially involving glands and reproductive organs.
Source & Preparation
• Prepared from mumps virus material (parotid gland secretion)
• Potentized according to homeopathic pharmacopeia
Acts on:
• Salivary glands
• Testes & ovaries
• Nervous system
Miasmatic Background
• Primarily acute miasm
• May show deeper action in sycotic/tubercular background
Constitution
Individuals with:
• History of mumps
• Glandular swellings
• Tendency to complications after viral infections
Mental state:
• Irritable
• Weak, exhausted
• Sensitive during illness
Key Indications
1. Mumps (Parotitis)
• Swelling of parotid glands
• Pain while chewing or swallowing
• Fever with malaise
• Dry mouth
2. Glandular Affections
• Enlarged salivary glands
• Suppuration (rare)
• Chronic glandular swelling
3. Testicular Involvement (Important)
• Orchitis after mumps
• Pain and swelling of testes
• Risk of infertility
4. Ovarian Involvement
• Oophoritis after mumps
• Pelvic pain
• Menstrual disturbances
5. Nervous System
• Meningitis (rare complication of mumps) • Headache and weakness
Modalities
Aggravation (Worse):
• Cold exposure
• Touch or pressure
• Movement (chewing)
Amelioration (Better):
• Warmth
• Rest
Clinical Uses
• Mumps (acute stage)
• Prevention of complications
• Orchitis and oophoritis
• Chronic glandular enlargement
• Post-mumps weakness
Prophylactic Use
• Used during mumps outbreaks
• Helps reduce severity and complications
Relationship with Other Remedies
Complementary Remedies:
• Belladonna
• Mercurius solubilis
• Pulsatilla
• Compare with:
• Rhus toxicodendron (glandular pain with stiffness)
• Apis mellifica (swelling with stinging pain)
Dosage & Repetition
• Common potencies: 30C, 200C
• Acute stage: repeated doses
• Chronic/complications: single dose with observation
- Variolinum
Introduction
• Variolinum is a homeopathic nosode prepared from the virus of smallpox. • It is mainly used in smallpox-like conditions, skin eruptions, and as a prophylactic remedy.
Source & Preparation
• Prepared from smallpox vesicle/pustular matter
• Potentized according to homeopathic pharmacopeia
Acts mainly on:
• Skin
• Blood
• Immune system
Miasmatic Background
Primarily acute miasm
• Also shows syphilitic miasmatic influence (destructive lesions, ulceration)
Constitution
Individuals with:
• Tendency to severe skin eruptions
• Weak immunity
• History of eruptive fevers
Mental state:
• Irritable
• Weak and prostrated
• Restlessness during fever
Key Indications
1. Smallpox-like Conditions
• High fever with severe backache
• Eruptions progressing from macules → papules → pustules
• Offensive discharges
• Marked prostration
2. Skin Disorders
• Pustular eruptions
• Boils and ulcers
• Scarring after eruptions
• Chronic skin infections
3. Septic & Toxic States
• Blood poisoning tendencies
• Severe infections with foul discharges
4. General Symptoms
• Intense backache (characteristic)
• High fever with chills
• Weakness and exhaustion
Modalities
Aggravation (Worse):
• Night
• Cold air
• During eruption stage
Amelioration (Better):
• Warmth
• Rest
Clinical Uses
• Smallpox (historical use)
• Chickenpox (varicella) supportive cases
• Pustular skin diseases
• Boils and ulcers
• Post-eruptive weakness
Prophylactic Use (Important)
• Historically used to prevent smallpox
• May be used in eruptive epidemics
Relationship with Other Remedies
Complementary Remedies:
• Vaccininum
• Thuja occidentalis
• Sulphur
• Compare with:
• Rhus toxicodendron (vesicular eruptions)
• Antimonium tartaricum (pustular eruptions with weakness)
Dosage & Repetition
• Common potencies: 30C, 200C, 1M
• Usually given as single dose
3. Psoric / Miasmatic Nosodes
Prepared from disease products related to chronic miasms.
Examples:
A)Psorinum
Introduction
• Psorinum is a major homeopathic nosode prepared from the sero-purulent discharge of scabies vesicles.
• It is one of the principal anti-psoric remedies in homeopathy.
Source & Preparation
• Prepared from vesicular fluid of scabies lesions
• Potentized according to homeopathic pharmacopeia
Acts deeply on:
• Skin
• Nervous system
• Digestive system
• Immune system
Miasmatic Background
• Strongly related to Psoric miasm
• Represents deficiency, hypersensitivity, and chronic weakness
Constitution
• Dirty, greasy, unhealthy-looking skin
• Offensive body odor despite washing
• Poor hygiene appearance even if clean
Mental traits:
• Hopelessness (feels recovery is impossible)
• Depression and despair
• Anxiety about future
• Lack of confidence
Key Indications
1. Skin Disorders
• Eczema, psoriasis, scabies-like eruptions • Intense itching, worse at night
• Dirty, greasy skin
• Suppressed skin diseases
2. Respiratory System
• Chronic asthma
• Recurrent colds
• Cough worse in winter
3. Digestive System
• Indigestion
• Offensive stools
• Lack of appetite
4. General Symptoms
• Extreme weakness
• Chilly patient (cannot tolerate cold) • Wants warm clothing even in summer • Profuse offensive sweat
Modalities
Aggravation (Worse):
• Cold weather
• Winter
• Bathing
• Night
Amelioration (Better):
• Warmth
• Warm clothing
• After eating
Clinical Uses
• Chronic eczema & psoriasis
• Asthma with skin history
• Recurrent infections
• Chronic weakness and debility
• Non-reactive cases (when remedies fail)
Relationship with Other Remedies
Complementary Remedies:
• Sulphur
• Calcarea carbonica
• Lycopodium clavatum
• Compare with:
• Sulphur (heat, burning)
• Graphites (thick, sticky eruptions)
Dosage & Repetition
• Usually given in high potencies (200C, 1M)
• Single dose followed by long observation
• Avoid frequent repetition
B)Medorrhinum
Introduction
• Medorrhinum is a deep-acting homeopathic nosode prepared from gonorrheal discharge. • It is one of the principal anti-sycotic remedies in homeopathy.
Source & Preparation
• Prepared from urethral discharge of gonorrhea patients
• Potentized according to homeopathic pharmacopeia
Acts deeply on:
• Genito-urinary system
• Nervous system
• Skin and mucous membranes
Miasmatic Background
• Strongly related to Sycotic miasm
• Represents:
• Excess
• Overgrowth
• Suppression of disease
Constitution
Individuals with:
• History of suppressed gonorrhea
• Chronic pelvic or urinary issues
• Recurrent infections
Mental traits:
• Extreme behavior (either very active or very dull) • Impulsive, hurried
• Forgetful
• Loves excitement, thrill-seeking
Key Indications
1. Genito-Urinary System
• Chronic urethritis
• Frequent urination
• Burning urination
• Gonorrheal complications
2. Female Disorders
• Leucorrhoea (thick, offensive)
• Ovarian pain
• Infertility
• Menstrual irregularities
3. Skin Disorders
• Warts (sycotic growths)
• Moist eruptions
• Itching and burning
4. Respiratory System
• Asthma (especially at night)
• Chronic bronchitis
5. General Symptoms
• Extreme fatigue or hyperactivity
• Sleeps in knee-chest position
• Craves sour fruits, ice
• Burning sensation in body
Modalities
Aggravation (Worse):
• Night
• Damp weather
• Sea air
Amelioration (Better):
• Lying on abdomen (knee-chest position) • Dry weather
Clinical Uses
• Gonorrheal complications
• Chronic urinary infections
• Infertility
• Warts and growths
• Asthma with sycotic background
Relationship with Other Remedies
Complementary Remedies:
• Thuja occidentalis
• Natrum sulphuricum
• Pulsatilla
• Compare with:
• Thuja occidentalis (fixed ideas, warts) • Nitric acid (ulceration, fissures)
Dosage & Repetition
• Common potencies: 200C, 1M
• Given in single dose with long observation • Avoid frequent repetition
C)Syphilinum
Introduction
• Syphilinum is a deep-acting homeopathic nosode prepared from syphilitic material. • It is one of the main anti-syphilitic remedies, used in destructive and degenerative conditions.
Source & Preparation
• Prepared from discharges of syphilitic lesions
• Potentized according to homeopathic pharmacopeia
Acts deeply on:
• Bones
• Nervous system
• Skin and mucous membranes
Miasmatic Background
• Strongly related to Syphilitic miasm
• Represents:
• Destruction
• Ulceration
• Degeneration
Constitution
Individuals with:
• History of syphilis or inherited taint
• Chronic destructive diseases
• Bone and nerve involvement
Mental traits:
• Hopelessness
• Despair
• Fear of night
• Memory weakness
Key Indications
1. Bone & Skeletal System
• Bone pains, especially at night
• Caries and necrosis
• Deformities
2. Skin & Ulceration
• Deep ulcers
• Non-healing wounds
• Destructive skin lesions
3. Nervous System
• Paralysis
• Neuralgia
• Degenerative neurological disorders
4. General Symptoms
• Symptoms worse at night (very characteristic) • Sleeplessness
• Extreme weakness
Modalities
Aggravation (Worse):
• Night (keynote )
• Cold and damp
• Winter
Amelioration (Better):
• Daytime
• Warmth
Clinical Uses
• Syphilitic conditions
• Bone diseases
• Chronic ulcers
• Neurological degeneration
• Non-healing chronic cases
Relationship with Other Remedies
Complementary Remedies:
• Mercurius solubilis
• Kali iodide
• Aurum metallicum
• Compare with:
• Mercurius solubilis (offensive discharges)
• Nitric acid (ulcers with fissures)
Dosage & Repetition
• Common potencies: 200C, 1M
• Given as single dose
• Long observation required
Indications for Prescribing Nosodes
Nosodes are commonly prescribed in the following situations:
• When well-selected remedies fail to act despite correct prescribing.
• In chronic and deep-seated diseases associated with miasmatic background.
• In recurrent diseases (e.g., recurrent infections, repeated colds).
• When the symptom picture corresponds to the nosode in materia medica.
• In family history of chronic diseases like tuberculosis, cancer, syphilis etc.
• As an intercurrent remedy during long-term treatment.
Nosodes as Intercurrent Remedies:-
• In clinical practice, nosodes are frequently used as intercurrent remedies.
• This means they are prescribed between two remedies to remove obstacles to cure and stimulate the vital force.
• Example:Chronic eczema not responding → Psorinum 200 intercurrently.
Precautions in Prescribing Nosodes
• Nosodes should not be prescribed routinely.
• Selection must be based on totality of symptoms or miasmatic background.
• Use appropriate potency and repetition carefully.
• Avoid frequent repetition without clear indication.
Conclusion
• Nosodes play an important role in homeopathic clinical practice, especially in chronic and miasmatic diseases. When used judiciously, they can remove obstacles to cure and help restore the patient’s vital force. However, they should be prescribed carefully and only when clearly indicated.
Reference
- An update on bowel Nosodes with comparison by Dr chaturbhuja Nayak
- Julian’s material of nosodes with repertory treatised on dynamised micro-immunotherapy by Rajkumar Mukherji
About the Guide:
Dr Mukesh Sharma , MD (HOM)
• Professor, Department of Homeopathic Materia Medica
• District Homeopathic medical College and Hospital, Ratlam (M.P.)

